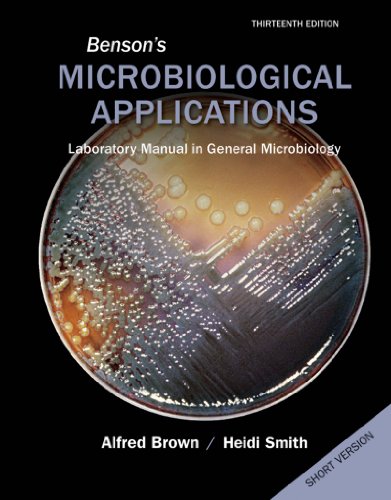

Benson's Microbiological Applications Short Version: Laboratory Manual in General Microbiology
Product Description
Condition - Very Good
The item shows wear from consistent use but remains in good condition. It may arrive with damaged packaging or be repackaged.
Benson's Microbiological Applications Short Version: Laboratory Manual in General Microbiology
Benson's Microbiological Applications has been the gold standard of microbiology lab manuals for over 30 years. The self-contained, clearly-illustrated exercises and four-color format makes this the ideal lab manual. Appropriate for either a majors or non-majors lab course, this manual assumes no prior organic chemistry has been taken. Use McGraw-Hill's Learning Solutions to make this manual fit your exact course needs! Add or remove exercises, include your own material, re-order to fit your course - the possibilities are endless.







